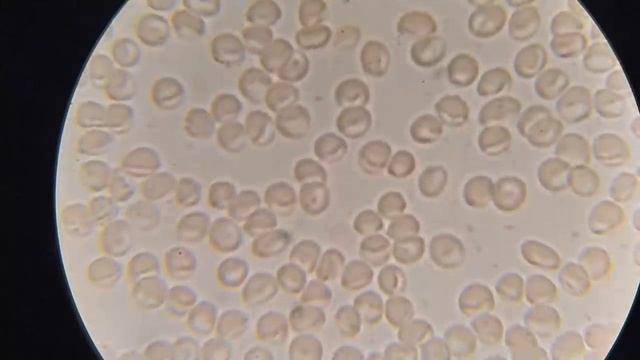
Кровь после масла и семян чёрного тмина смотреть онлайн

Автор / Канал: Фотография Природы и Ландшафтов Страница 4

Как сделать вкусные шкварки - рецепт

Мы Сравнили 7 видов Соли. Гималайская Соль, Розовая Соль

Хлеб рисунок. Рисунок хлеб всему голова. Рисунок на тему хлеб. Еда рисунок. Как нарисовать хлеб.

Новогодний салат с креветками)Вкуснее вы ещё точно не ели.

Секретные фишки на авито которые делают деньги. Как делать продающие объявления.

Салат "Марсель"

Профитроли в шоколаде

Making Mandarin Marmalade: An Easy Recipe

Салат с креветками.Сбалансированный ужин.По метаболическому принципу.ПП салатик?

СУПЕР ТЕСТО ДЛЯ ЧЕБУРЕКОВ?? ЧЕБУРЕКИ С КАРТОШКОЙ И ЛУКОМ, НАИВКУСНЕЙШИЕ???ВЧЕРАШНЯЯ СУПОВАЯ ЗАПРАВК
Кровь после масла и семян чёрного тмина

Ферганский плов в Ташкенте

Тушена качка кусочками у власному соці

Турецкая окрошка на кефире (Джаджик) | Холодный суп от жары и для диеты

Дегустируем корейскую соевую пасту Дендян в зеленой коробке

Куча дел//жареная картошечка//7 марта 2023 г.

Ravioli

Мясо по-китайски в кисло-сладком соусе.

Бачаи узбек духтари уруса дар метро чи кор кард?

Реклама Макдоналдс Острые Чикен Макнаггетс Бхарат

ЕЩЕ ОДИН ДОМ С УДОБНОЙ ПЛАНИРОВКОЙ. ДОМА ВО ФЛОРИДЕ.

Щербет, что это такое и с чем его едят?

Пробуем 10 ДОРОГИХ КОРЕЙСКИХ ДОШИРАК ! Битва РАМЕН !

Шампиньоны гриль
За каждым успешным каналом стоит личность, идея и сотни часов кропотливого труда. Если вы здесь, значит, автор «Фотография Природы и Ландшафтов» уже сумел зацепить ваше внимание своим уникальным стилем или подачей. А мы на RUVIDEO позаботились о том, чтобы вы могли изучить весь архив его работ в максимально комфортных условиях — без лишней суеты и преград.
Почему за работами канала «Фотография Природы и Ландшафтов» так интересно наблюдать? Всё просто: это честный контент, который находит отклик в сердцах зрителей. На нашем ресурсе вы можете смотреть онлайн все видео любимого автора бесплатно и в хорошем качестве. Нам важно, чтобы вы видели каждую деталь и слышали каждый нюанс, поэтому мы используем только стабильные плееры из открытых источников Rutube.
Следите за новинками канала, пересматривайте старые шедевры и открывайте для себя новые грани творчества «Фотография Природы и Ландшафтов». Мы постоянно обновляем ленту, чтобы у вас под рукой всегда были самые свежие выпуски. Никаких сложных регистраций — только вы и творчество, которое вдохновляет. Приятного вам путешествия по миру авторского контента на RUVIDEO!
Видео взято из открытых источников Rutube. Если вы правообладатель, обратитесь к первоисточнику.